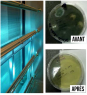

RÉDUIRE LES RISQUES DE TRANSMISSION DE VIRUS
Plusieurs d’entre vous doivent présentement prendre d’importantes décisions tout en jonglant avec des effectifs réduits. Sachant qu’une bonne maintenance du bâtiment diminuent vos coûts d’énergie et contribuent à réduire la transmission d’agents pathogènes, voici quelques conseils de maintenance au-delà de ceux liés au nettoyage et à la désinfection des surfaces.
Laissez vos systèmes d’apport d’air frais fonctionner en permanence, jour et nuit
Remplacez vos jeux de filtres à intervalles réguliers
Bonifier les équipements de vos systèmes CVAC
Filtration de l’air
Les particules dans l’air ambiant sont un véhicule de transport de virus. La filtration de l’air est donc d’une grande importance afin de réduire le risque de transmission.
L’efficacité à laquelle les particules sont éliminées par les filtres dans les systèmes CVAC varie considérablement selon le type de filtre utilisé et la taille des particules. La norme d’ASHRAE 52.2 répertorie 20 classes de filtres MERV (Minimum Efficiency Reporting Value) selon leur efficacité à éliminer les différentes grosseurs de particules. Un MERV plus élevé élimine donc un plus grand nombre de particules.

Actuellement, la plupart des systèmes CVAC de bâtiments commerciaux et résidentiels sont munis de filtres ayant un rendement relativement faible. Les coûts supplémentaires liés à l’utilisation de filtres à efficacité plus élevée sont modestes, et les avantages prévus pour la santé sont considérables.
La désinfection de l’air grâce à la lumière ultraviolette (UV)
Dans les systèmes en recirculation, la désinfection de l’air peut également se faire au moyen de la lumière UV, bien que cette technique ne soit pas efficace à 100 %.

La lumière UV est une forme de lumière invisible pour l’œil humain. Elle occupe la partie du spectre électromagnétique comprise entre les rayons X et la lumière visible. Le soleil émet de la lumière UV; cependant, la plus grande partie en est absorbée par la couche d’ozone terrestre.
Le rayonnement UVC attaque les micro-organismes au niveau moléculaire, désactivant et détruisant les contaminants. Parallèlement, le rayonnement UVV dégrade les composés organiques volatils (COV) chimiques et les odeurs.
Bénéfice d’une installation UV
La longueur d’onde (UVC 254nm) pour la phrase de stérilisation est bien connue pour ses propriétés hautement germicides. L’effet du rayonnement ultraviolet sur les bactéries est abondamment documenté. Il existe plusieurs applications possibles, soit dans les conduits de ventilation, serpentins ou à l’intérieur d’une pièce.

Pour plus d’information, n’hésitez pas à communiquer avec nous, il nous fera plaisir de vous conseiller sur les astuces de maintenance à mettre en place afin de diminuer les risques de contamination reliés aux systèmes de ventilation.
Appelez-nous



